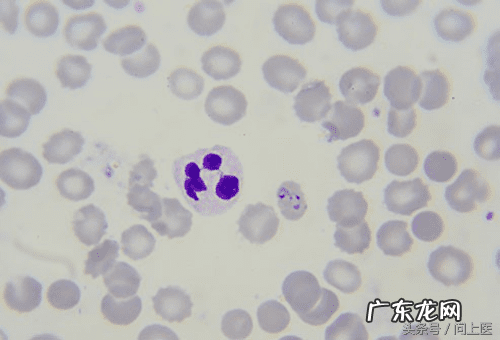
十大寄生虫病 寄生虫病症状

8 / 15 克氏锥虫

文章插图
这种寄生虫会导致美洲锥虫病(Chagas disease),而这种疾病会危及生命 。人们如果接触了含有这种细菌的粪便就会感染 。症状表现为发热、疲劳、疼痛、头痛、皮疹、食欲不振、腹泻、呕吐和眼睑肿胀 。之后,它会导致心脏和肠道问题 。医生可以用药物治疗疾病并杀死寄生虫 。
9 / 15 隐孢子虫

文章插图
这种虫子也叫“秘密成员”,它会影响人的肠道 。它可以通过受感染的人或动物的粪便进行传播(粪便传播) 。人们很容易通过接触泳池的水而被传播,尤其是孩子 。它引起的腹泻可以持续很长一段时间,但它通常可以在没有治疗的情况下自行消失 。
10 / 15 恶性疟原虫
文章插图
一些蚊子会携带这种会导致疟疾的寄生虫 。相比于其他任何一种恶性疟原虫导致的疾病,疟疾杀死的人是最多的 。感觉就像流感,疟疾会引起身体发冷、发烧、有时还会恶心或呕吐 。医生必须在显微镜下观察病人的血液样本才能判断他们体内是否有恶性疟原虫 。早期治疗是最好的,某些处方药可以治疗大多数恶性疟原虫引起的疾病 。
11 / 15 阴道毛滴虫

文章插图
这种寄生虫会导致一种叫做滴虫病的性传播疾病——一种最常见的可治愈的性传播疾病 。大多数感染者没有任何症状,但有些人可能会注意到他们的阴茎或阴道有瘙痒、灼烧或刺激感 。这种病可以使用抗生素治疗 。
12 / 15 枯草芽孢杆菌

文章插图
医生无法确定患者是如何感染这种会感染大肠的寄生虫的 。有些人会胃痛和腹泻,但其他人没有症状 。这在世界各地都很常见 。医生可以开药帮助缓解 。
13 / 15 弓形虫

文章插图
这种细菌可在肉类、水中和受感染的猫的粪便中繁殖 。它会引起弓形虫病,这种病有点像流感 。孕妇和免疫系统弱的人可能会有严重的症状,比如肌肉、大脑和眼睛的囊肿 。通常无需治疗,但是医生可以给严重的感染者开处方药 。
14 / 15 麦地那龙线虫

文章插图
人们如果饮用了被幼虫感染的水就会被感染 。蠕虫会在胃里交配和生长,然后通过皮肤上的水泡爆发出来 。症状包括发烧、肿胀和水泡附近疼痛,但通常一年之后才会出现这些迹象 。这种疾病没有治疗方法 。
15 / 15 寄生虫对人有好处吗?

文章插图
寄生虫带给人们的都是一些坏处,但一些研究人员正试图找出它们是否也能被有益利用 。对“蠕虫疗法”的研究表明,它可以帮助缓解结肠炎、克罗恩病、I型糖尿病和哮喘的症状 。它在美国仍处于试验阶段 。
- 最好用的瘦身霜 瘦身霜十大品牌排行榜
- 无症状感染者核酸能检测到吗
- 珠穆朗玛峰十大死尸姓名 珠穆朗玛峰十大死尸
- 世界十大著名画作排名 世界十大著名画作
- 吃燕窝的十大禁忌「燕窝怎么吃比较好」
- 十大营销策略有哪些2020-2021 十大营销策略有哪些
- 四川攀枝花十大旅游景点
- 祛斑产品十大排行榜最新 祛斑产品十大排行榜
- 世界十大旅游景点图片 世界十大旅游景点
- 痔疮早期的症状是什么 痔疮早期的症状
特别声明:本站内容均来自网友提供或互联网,仅供参考,请勿用于商业和其他非法用途。如果侵犯了您的权益请与我们联系,我们将在24小时内删除。
